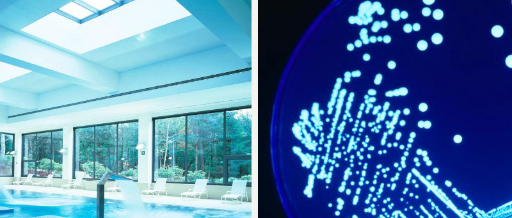

PREVENCIÓN LEGIONELOSIS
Obligatorio para los hoteles y establecimientos con sistemas de agua caliente sanitaria con acumulador sistemas de instalación interna de agua fría, spas, jacuzzis, etc., para garantizar que no presenten riesgo para la salud pública.
Esgasem S.L., con númerp de inscripción 06-390169-09-SP en el Registro Oficial de Establecimientos y Servicios Plaguicidas, ha desarrollado las siguientes funciones para la prevención de la legionelosis, sigún el R.D. 865/2003
Leer REAL DECRETO 865/20036. MINISTERIO DE SANIDAD Y CONSUMO
Diseño y desarrollo de sistemas para la prevención de la legionelosis en instalaciones de riesgo, con evaluación del grado de adecuación de las instalaciones de agua caliente sanitaria y del agua fría de consumo humano.
Tratamientos de limpieza y desinfección de las instalaciones, implantación y seguimiento del progra de mantenimiento periódico y de la cumplimentación del Libro de Registro.
Recogida de muestras para el análisis microbiológico del agua y gestión de resultados.
Documento Adobe Acrobat [117.1 KB]